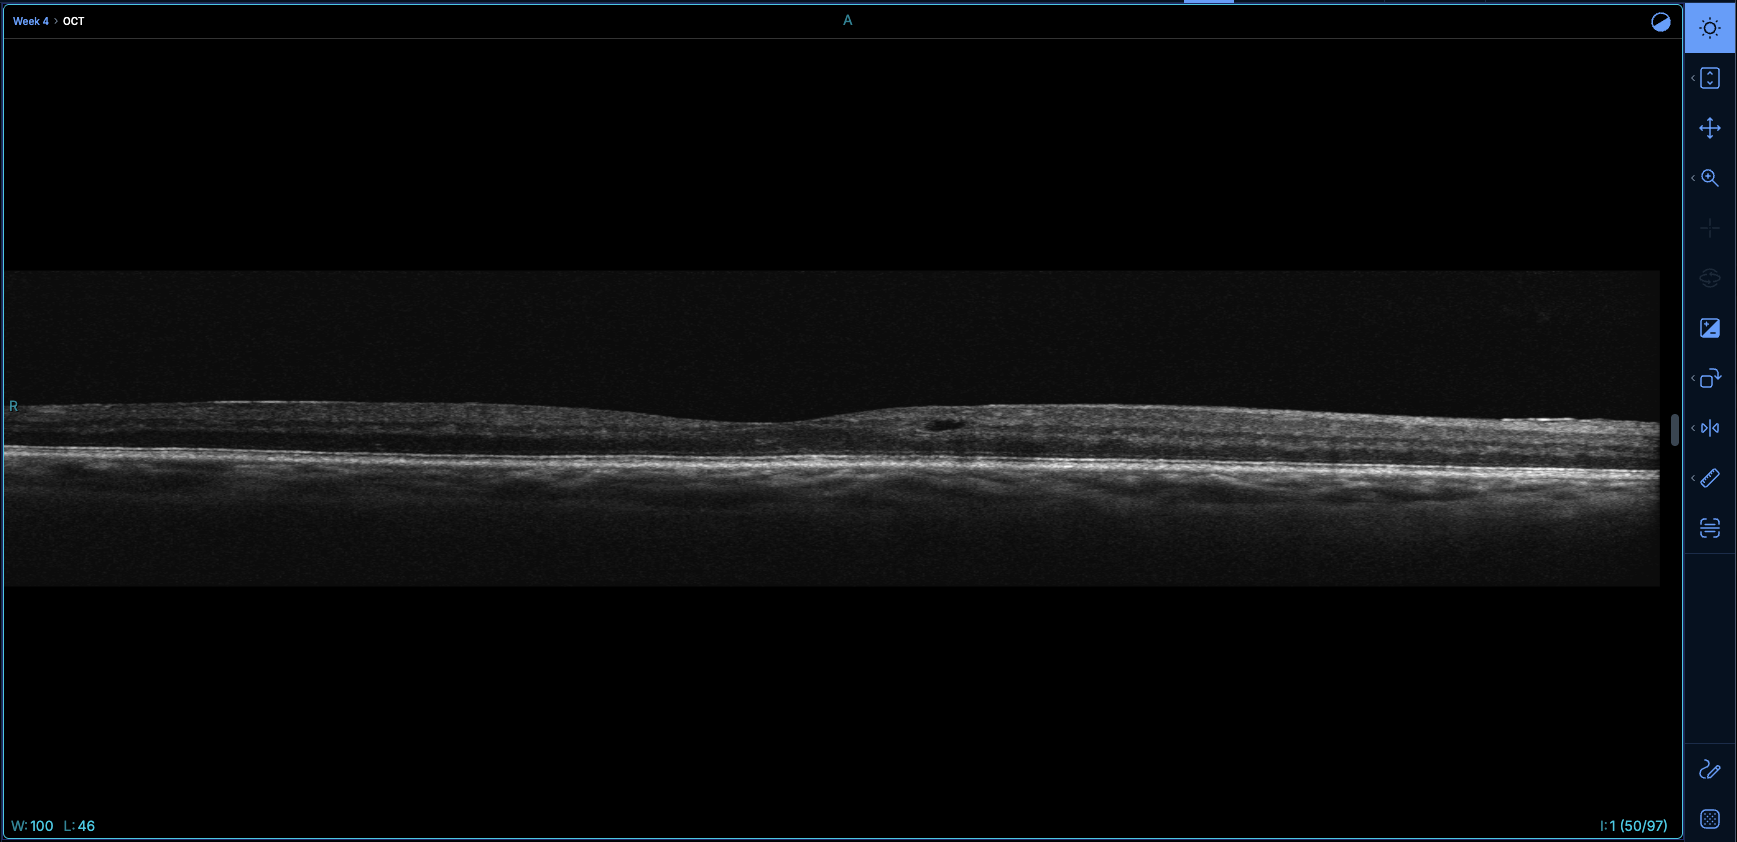
Normal aspect ratio

Getting started with the V3 viewer
Introduction
Flywheel is excited to introduce its new V3 viewer, available on all sites running v.19.3 or later. Based on the open-source OHIF v3 viewer that leverages the Cornerstone3D library it brings significant improvements in multi-dimensional data visualization and segmentation. Additionally the viewer has been completely redesigned to provide Flywheel users with a unique viewing experience.
The V3 viewer is currently available to users as a secondary viewer by default, with the V2 viewer being the main viewer. If you are interested in having the V3 viewer as your default viewer please contact your sales representative.
Launching the viewer
There are multiple ways to open the V3 viewer from Flywheel depending on where you are on the platform what you are trying to do. Please note that the V3 viewer will open in a separate browser tab.
For sites where the V3 viewer is not the default viewer (most common), the V3 viewer can only be launched at the file level.
At the project level
Warning
If your site is not configured to have the V3 viewer as the default viewer this option will not be available and will launch the V2 viewer instead. If you would like to make the V3 viewer your default viewer, please contact your sales representative.
From a project's Description page, users can click on the Viewer Study List. This opens a list of all the sessions that exist in the project where each session and file can be opened in the viewer.

At the session level
Warning
If your site is not configured to have the V3 viewer as the default viewer this option will not be available and will launch the V2 viewer instead. If you would like to make the V3 viewer your default viewer, please contact your sales representative.
If you're only interested in viewing images from the same session, you can open the viewer at the session level. From the a project's session page click on the viewer icon next to the session you would like to open in the session list. You can also select a session from the session list, and click Launch in Viewer.

Note
If your session has multiple acquisitions, only the images from the first acquisition will be initially loaded in the left-side panel of the viewer. To load images from the other acquisitions use the file browser. See [Loading more files into the left-side panel]
At the file level
Sites where the V3 viewer is the default viewer
For DICOM files, the Launch in Viewer button opens the file in the V3 viewer.

For non-DICOM files (such as NIfTI, TIFF, PNG, JPEG, or MHD/RAW), the Launch in Viewer button launches the V2 viewer because the V3 viewer does not support these formats.
Sites where the V3 viewer is not the default viewer (most common)
For sites where the V3 viewer is not the default viewer, the Launch in Viewer button launches the V2 viewer. The V3 viewer can only be launched at the file level by clicking the three-dots icon ![]() next to the file name on the acquisitions page and selecting Launch in Viewer (V3).
next to the file name on the acquisitions page and selecting Launch in Viewer (V3).

Viewer overview
The viewer is divided in four main components:
The viewport
The viewport is the area of the viewer where images are being displayed. By default, the first image dataset in the left-side panel will be automatically displayed in the viewport upon opening the viewer (see also launching the viewer). Multiple viewports can be added to create a multi-viewport layout and visualize multiple images simultaneously (see Layout selection).
Additional information and menus are available in each viewport:
- Top left corner: Flywheel session name and Flywheel acquisition name for the image file being displayed.
- Top right corner: Viewport settings/rendering controls (see below)
- Bottom left corner: Window Width (W) and Window Level (L)
-
Bottom right corner: Slice/instance number

Default mouse controls in the viewport
The default mouse controls in the viewport are described in the table below.
| Mouse button | Function |
|---|---|
| Left | Active tool (Window levels by default) |
| Right | Zoom |
| Middle | Move (Pan) |
| Mouse wheel | Scroll |
Viewport rendering controls
Each viewport comes with its own rendering controls to apply settings like color maps or window level presets. Only settings that are relevant to that viewport are available and vary depending on the image modality or the type of viewport (2D vs 3D).

- List of controls available for 2d viewports
| Setting | Modality | Description |
|---|---|---|
| Display Color Bar | All modalities | Displays a color bar on the right-side of the viewport. Window levels can be modified by clicking on the color bar and dragging the mouse up and down or left and right. |
| Color LUT | All modalities | Changes the colormap used to render the image. The following lookup tables are available: Grayscale, X ray, HSV, Hot Iron, Red Hot, S PET, Perfusion, Rainbow, SUV, GE 256, GE, Siemens. Note: select "Preview in viewport" and hover over the list of colormaps to see a preview in the viewport. |
| Window presets | CT | Applies a pre-defined window width and window level to the image. The available window presets are Soft tissue, Lung, Liver, Bone, and Brain. |
| RGB filter | Color images | Allows to select a single channel (Red, Green or Blue) or manually adjust each channel's intensity |
- List of controls available for 3D viewports
| Setting | Modality | Description |
|---|---|---|
| Rendering Presets | All modalities | Allows users to select from a list of 22 rendering presets |
| Rendering Options | All modalities | Allows to modify rendering settings like quality and shift. Also allows to adjust the ambient, diffuse and specular light. |
RGB filter
The RGB filter controls are available for color images only (i.e. images where PhotometricInterpretation (0028,0004) is different than MONOCHROME1 or MONOCHROME2).

Unselect a channel to turn it off. When a single channel is selected, the image will automatically be displayed in grayscale. The intensity of each channel can be adjusted separately by moving the sliders.
Tip
Use the quick keys Shift + R, Shift + G or Shift + B to quickly select a single channel.
The left-side panel
The left-side panel is where users can browse the data that they would like to view in a viewport. Image files are represented by thumbnails are grouped by their Flywheel session. Sessions can be collapsed for a better browsing experience.


Tip
The left-side panel can be collapsed or expanded using the [ hotkey.
Loading an image into a viewport
Image files and overlay files such as DICOM structured reports DICOM SEG files or DICOM RTSTRUCT files can be loaded into a viewport either by dragging and dropping or by double-clicking on a thumbnail. When using the double-click files will be loaded in the active viewport (identified by a thicker and different color border). Clicking anywhere in a viewport automatically makes it the active viewport. When a multi-viewport layout is being used, thumbnails of the files being displayed in the active viewport are highlighted in the left-side panel.
In the example below, the left viewport is the active viewport and the sagittal image being displayed in the viewport is also highlighted in the left-side panel. 
In this next example, the active viewport is now the right viewport and the axial image being displayed in that viewport is highlighted in the right-side panel. 
Loading more files into the left-side panel
When the viewer is launched, the number of files already loaded in the left-side panel is limited. If the viewer is launched at the session-level only files from that session's first acquisition will be loaded in the left-side panel. If the viewer is launched at the file-level, only that file will be loaded in the left-side panel.
The left-side panel file browser allows users to load additional files from the same subject into the left-side panel to be viewed in the viewer. To open the file browser click on one of the Load Files icon located at the top and at the bottom of the left-side panel. The file browser retrieves an up-to-date list of files each time it is opened.

The file browser allows the user to browse all Flywheel files for that subject according to the Flywheel hierarchy:
- Session
- Acquisition
- File
- Acquisition
Sessions and acquisitions are represented as folders that can be expanded/collapsed. Upon opening the file browser, sessions and acquisition folders are collapsed, except for the ones containing files that are already loaded in the left-side panel. In the example below, only the T1w_MPR.dcm.zip file is already loaded in the left-side panel. Files that are not supported by the viewer are grayed out and cannot be unselected.

Load more files from the same acquisition
If you opened a file from an acquisition that contains multiple files, you can load the other files in that acquisition by opening the file browser selecting the files that you would like to load and click "Load into Viewer"

Load more files from a different acquisition in the same session
To load files from another acquisition, expand that acquisition's folder and select the files that you would like to load, then click "Load into Viewer".

Tip
If you want to load all files from an acquisition, you can select the acquisition folder. This will select all the supported files in that acquisition.
Load more files from a different session
To load files from another session, expand that session's folder and select the acquisitions/files that you would like to load, then click "Load into Viewer"

Tip
If you want to load all files from a session, you can select the session folder. This will select all the supported files from all acquisitions in that session.
Load files from analyses
If your session contains analyses files, there will be a Analyses sub-folder in that session's folder. Within this Analyses folder, analyses files are organized in sub-folders that each represent one analysis container. You can expand each analysis container to select individual analyses files to load into the left-side panel. Below is an example of analyses files as seen from the Flywheel session page (top) and how to load those same files from the file browser in the viewer (bottom).


Tip
If you want to load all files from an acquisition container, you can select the acquisition container folder. This will select all the supported files in that acquisition container.
Load files using the search bar
In cases where there are a lot of sessions and acquisitions for the same subject it could become difficult to browse through all the files to find the ones that need to be loaded. You can use the search bar in the file browser to quickly access the files that you would like to load.

Tip
The search term is used to filter on files but also on folders. If your search term is found in the name of an acquisition all files from that acquisition will be returned as a result of your search.
Loading behavior
When you launch multiple files in the viewer simultaneously, files load progressively in the left-side panel.
As soon as the first image thumbnail is available in the left-side panel, it can be loaded in the viewport. A progress bar for each thumbnail indicates whether all slices have been pre-fetched. While you can start reviewing images before all slices have been loaded, you may experience slight delays as you start scrolling to a slice that has not been loaded yet. Once the progress bar indicates that the image is fully loaded, all slices can be scrolled without any interruption.
The header toolbar

The header toolbar is where users can find and edit viewer settings and image display. It includes the following tools/menus:
- Layout selection
- Reference lines
- Viewport synchronization
- Cine mode
- Reset view
- Image capture
- Viewer mode selection
- Image information
- User avatar
- Viewer settings
Layout selection
Users can customize the viewer layout by adding more viewports using the layout selection menu.

Tip
In a multi-viewport layout any viewport can be maximized to a single-viewport view by double-clicking anywhere within that viewport. Another double-click reverts back to the previous multi-viewport layout.
Common layouts

Users can quickly select one of the most common viewport layouts:
- 1x1 viewport
- 1x2 viewports
- 2x2 viewports
- 2x3 viewports
Custom layouts

Users can customize their viewport layout by adding up to 12 viewports using the custom grid. By hovering over the grid to select rows and columns, users can pick any of following layouts:
- 1x1 viewport
- 1x2 viewports
- 1x3 viewports
- 1x4 viewports
- 2x1 viewports
- 2x2 viewports
- 2x3 viewports
- 2x4 viewports
- 3x1 viewports
- 3x2 viewports
- 3x3 viewports
- 3x4 viewports
Note
When adding more viewports to your layout the additional viewports will automatically display all images present in the left-side panel from the first session that launched in the viewer. If your layout includes more viewports than there are image datasets loaded in the left-side panel for that session those extra viewports will be empty.
Advanced layouts
Advanced layouts (except Frame view) are available when the image data in the active viewport is reconstructible (see requirements resource).
Multi-planar reconstruction (MPR)
The multi-planar reconstruction (MPR) layout consists of a 1x3 viewport layout where each viewport is showing one of the three orientations (axial, sagittal, coronal)

Note
If your image dataset is in an oblique orientation, one of the viewports will display the acquisition orientation.
3D four up
The 3 four up layout is a 2x2 viewport layout where the first row has the axial orientation and 3D rendering, and the second row has the coronal and sagittal orientations.

3D main
The 3D main layout is an asymmetric layout with two rows where the first row is one single viewport with 3D rendering and the second row has three viewports with the axial coronal and sagittal orientations.

Axial Primary
The axial primary layout is an asymmetric layout where the first column is one single viewport with the axial orientation and the second column has two viewports with the sagittal and coronal orientations.

3D only
The 3D only layout consists in one single viewport with 3D rendering.

3D primary
The 3D primary layout is an asymmetric layout where the first column is one single viewport with 3D rendering, and the second column has three viewports with the axial coronal and sagittal orientations.

Reference lines
The reference line tool can be used when multiple series with different orientations are being displayed in a multi-viewport layout. A reference line is displayed on inactive viewports that corresponds to the location of the slice being displayed in the active viewport.

Viewport synchronization

The viewport synchronization menu allows to synchronize user actions across multiple viewports.
Tip
If you want to synchronize all the user actions below, select "Link All" in the Viewport synchronization menu.
Scroll
When checked, scrolling is synchronized across viewports with datasets with the same orientation. Additionally, the slice location is also synchronized as the user starts scrolling.
Zoom
When checked, zooming in and out as well as moving ("pan") the image is synchronized across viewports with the same orientation.
Orientation
When checked, any rotation or flip of the image will be synchronized across viewports with the same orientation.
Window Levels
When checked, window levels are synchronized across viewports displaying the datasets from the same modality.
Cine tool
For image series that have multiple images the cine tool allows users to play those images in a cinematic loop. The speed of the cinematic loop can be adjusted from 1 frame per second (fps) to 90 fps.
Reset view
The reset view button can be used to reset the zoom, window levels and orientation of the image being displayed in the active viewport.
Tip
The view can also be reset with the Space key.
Image capture
The capture menu allows to download a screen capture of the active viewport. The following settings can be modified when downloading an image capture:
- File Name: Users can type in some free text for the name of the file that will be downloaded
- File Type: Image captures can be downloaded either in the
.jpgor the.pngformat. - Width and Height: Resolution of the image being downloaded. Minimum resolution is 100x100px maximum resolution is 10000x10000px. The dimensions ratio is locked by default but can be unlocked using the link icon.
- Show annotations: 2D annotations or contours from DICOM RTSTRUCT files can be shown/hidden on the image capture. (Note: ROIs from 3D segmentations cannot yet be shown on image captures)

Viewer mode
The V3 viewer currently supports two different modes: Basic Viewer and TMTV mode.
Image information

The image information menu provides information from the image metadata. By clicking on the information icon ![]() users can quickly check the following image metadata:
users can quickly check the following image metadata:
- Subject ID: from
PatientID (0010,0020) - Sex: from
PatientSex (0010,0040) - Age: from
PatientsAge (0010,1010) - MRN: from
PatientsName (0010,0010) - Thickness: from
SliceThickness (0018,0050) - Spacing: from
SpacingBetweenSlices (0018,0088) - Scanner: from
ManufacturerModelName (0008,1090)
Note
The information will be displayed only if the above DICOM tags are present in the image and have valid values.
DICOM Tag Browser

The DICOM Tag browser allows users to check the value of any DICOM tag for all image datasets already loaded in the left-side panel of the viewer. Users can first select the image dataset that they would like to check from the Series drop-down list. Then users can either scroll down the list of DICOM tags or they can search for a specific tag by typing the name of that tag in the search bar. For each series, the Instance Number slider can be used to check instance-specific tags.
Tip
The search bar can be used to filter on tag IDs, tag VRs, tag names or tag values.
Viewer Settings
The Viewer settings menu provides links to relevant resources like links to the Release Notes page, Flywheel's user forum , or Flywheel's support portal. It also provides the Flywheel version and the version of the web browser being used, which is usually helpful information to troubleshoot issues.

User preferences
Customized hotkeys
In the user preferences, users can customize the default hotkeys. For any of the functions listed, users can assign the hotkey that they would like to use. If a hotkey is already being used, a warning will be shown (see below). The same hotkey cannot be assigned to multiple functions. Customized hotkeys will persist until they are modified again by the user. To reset the hotkeys to the default settings, users can click on "Reset to Defaults"

The right-side toolbar
The right side toolbar includes all the tools needed for better visualization of images.

Window levels
This tool is selected by default upon opening the viewer. When the tool is selected, hold down the left button of the mouse anywhere in the viewport and move up and down to modify the window level or up and down to modify the window width.
Vertical stretch
The vertical stretch tool allows to change the aspect ratio of the image in the active viewport so that it appears stretched along the vertical (Y) axis. This is particularly helpful for Optical Coherence Tomography (OCT) images to allow better visualization of pathologies.
The tool allows to set the following aspect ratios:
- 1:1 (default)
- 1:2
- 1:4
- 1:8
By default the tool is set to "stretch" mode. Each click on the tool stretches the image by setting the next aspect ratio (1:1 -> 1:2 -> 1:4 -> 1:8). Once the last aspect ratio is reached (1:8), the tool automatically switches to "contract" mode, where each click contracts the image by setting the previous aspect ratio (1:8 -> 1:4 -> 1:2 -> 1:1).
Below is an example of an OCT image with a 1:1 aspect ratio (top) and the same image with a 1:2 aspect ratio (bottom).

Tip
You can use hotkeys to stretch (Y) or contract (Shift + Y) at any time.
Move image
When the move tool is selected, hold on the left button of the mouse to move the image anywhere within the viewport.
Tip
When the tool is not selected, use the middle button of the mouse (mouse wheel) to move the image.
Zoom
When clicking on the zoom button in the right-side toolbar, a menu appears with two options:
- Zoom: when this tool is active, zoom in and out on the image by holding down the left button of the mouse and move up and down anywhere in the viewport.
- Magnify: when this tool is active, zoom in on a specific location of the image by holding down the left button of the mouse in the viewport.
Tip
You can zoom in and out on the image by holding down the right button of the mouse and move up and down anywhere in the viewport, even when the zoom tool is not selected.
Crosshair
The crosshair tool is only available for advanced layouts that display planar reconstructions and provides a way to locate a specific part of the image in the different orientations. When the crosshair tool is active clicking anywhere in the viewport will move the crosshair to that location in all three orientation viewports.
Custom orientation reconstruction
With the crosshair tool, users can visualize a planar reconstruction of their dataset in any orientation. To change the orientation of a reconstruction hover over one of the crosshairs to reveal a couple of dots. Click on the dot that is the furthest away from the crosshairs intersection and drag the mouse in any direction to rotate the crosshair. This will change the orientation of the reconstruction displayed in the other viewports.
Maximum intensity projection (MIP)
The crosshair tool can also be used to create a maximum intensity projection MIP) of an image. Hover over one of the crosshairs to reveal a couple of dots. Click on the dot that is the closest to the crosshairs intersection and drag the mouse in the direction perpendicular to the crosshair to increase the slab thickness. This creates a maximum intensity projection in the viewport displaying the reconstruction represented by that crosshair. The MIP view can then be rotated by rotating the crosshair (see below).
Tip
The crosshair position, orientation and slab thickness can be reset at anytime using the Reset View button in the header toolbar.
3D rotation
The 3D rotation tool is only available for 3D viewports and is selected by default when the active viewport is a 3D viewport. When the tool is active click anywhere in the viewport and drag the mouse in any direction to rotate the 3D rendering.
Tip
The 3D rendering orientation can be reset by using the Reset View button in the header toolbar.
Invert colors
The invert tool can be used to invert the colors of the image. Simply click on the tool, or use the hotkey I to invert the colors of the active viewport.
Rotate images

Images can be rotated 90 degrees to the right by clicking "Rotate right" or using the hotkey R. Images can be rotated 90 degrees to the left by clicking "Rotate left" or using the hotkey L.
Note
If you have selected to synchronize the orientation across viewports, the rotation will also apply to those viewports.
Flip images

Images can be flipped vertically by clicking "Flip vertically" or using the hotkey V. Images can be flipped horizontally by clicking "Flip horizontally" or using the hotkey H.
Note
If you have selected to synchronize the orientation across viewports, the flip will also apply to those viewports.
Annotations tools

Expand the tool menu to select the tool that you would like to use. The icon in the toolbar will change to the most recently used tool. See Annotate images for more details on annotation tools and how to use them.
Stack scroll
The stack scroll tool allows to scroll through image slices simply by holding down the left button of the mouse and dragging it up and down.
Tip
Use the mouse wheel to scroll through image slices at any time.
Measurements panel
The measurements panel icon allows to expand or collapse the measurements panel. For more details on measurements, see Annotate images
Segmentation panel
The segmentation panel icon allows to expand or collapse the segmentation panel. For more details on segmentations, see 3D segmentations
Default hotkeys
- Default hotkeys for viewport actions
| Key | Tool |
|---|---|
z | Activate the zoom tool |
+ | Zoom in in the active viewport |
- | Zoom out in the active viewport |
R | Rotate the image to the right in the active viewport |
L | Rotate the image to the left in the active viewport |
H | Horizontal flip in the active viewport |
V | Vertical flip in the active viewport |
C | Activate the cine tool |
I | Invert the image colors in the active viewport |
Y | Stretch image vertically |
Shift + Y | Contract image vertically |
end | Scroll to the last slice in the active viewport |
home | Move to the first slice in the active viewport |
down arrow | Scroll to 'Next image' in the active viewport |
up arrow | Scroll to 'Previous image' in the active viewport |
Space | Reset the view in the active viewport |
- Hotkeys for window level presets (available for CT images only)
| Key | Window level preset |
|---|---|
1 | Soft tissue, window: '400', level: '40' |
2 | Lung, window: '1500', level: '-600' |
3 | Liver, window: '150', level: '90' |
4 | Bone, window: '2500', level: '480' |
5 | 'Brain', window: '80', level: '40' |
- Hotkeys for RGB filter (available for color images only)
| Key | Action |
|---|---|
Shift + R | Select the red channel only |
Shift + G | Select the green channel only |
Shift + B | Select the blue channel only |
- Hotkeys for annotations/segmentation tools
| Key | Function |
|---|---|
Ctrl + Mouse scroll | Modify the radius of segmentation tools such as Brush, Eraser and Threshold Brush |
Ctrl+Z | Undo action |
Ctrl+Y | Redo action |
